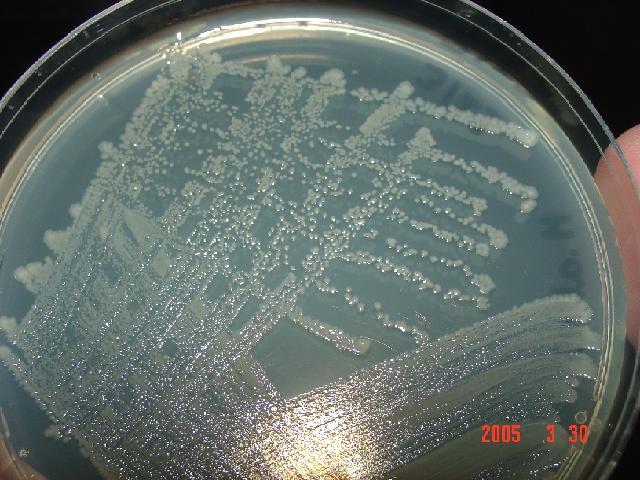

A éste último grupo de enterobacterias me gusta llamarlas "las figuritas difíciles del álbum" pues son raras de encontrar y de aislar.
Hafnia alvei es un bacilo gram negativo, única especie del género Hafnia, de la familia Enterobacteriaceae, y que durante mucho tiempo fue incluida en el género Enterobacter, hasta el desarrollo de las técnicas de biología molecular, que determinaron su separación, con definición de un nuevo género. Se encuentra ampliamente disperso en la naturaleza, en lugares como aguas residuales, suelo, oro ? faringe humana, intestino delgado y heces de personas y animales siendo habitualmente un microorganismo colonizador.
Se trata de un microorganismo facultativo, usualmente no patógeno, que se ha aislado de cultivos orgánicos (faringe, bronquio, sangre, orina y heces), produciendo infecciones en la gran mayoría de los casos, en pacientes con enfermedad crónica de base, inmunodeprimidos y en relación con estancias hospitalarias y utilización de antibioticoterapia de amplio espectro.
En los casos descriptos en la literatura el aislamiento de Hafnia alvei se asocia a flora polimicrobiana, siendo difícil establecer su implicación como agente causal. En la bibliografía revisada (MEDLINE de los últimos 10 años) se han descrito casos de gastroenteritis, enterocolitis necrotizante, colecistitis piógena, peritonitis, meningitis, infecciones del tracto urinario, abscesos cutáneos, endoftalmitis, bacteriemias, endocarditis, neumonía, empiema e infecciones de heridas en enfermos hospitalizados.
H. alvei es un bacilo cuyo nombre es enterobacter hafniae y puede ser responsable de infecciones graves adquiridas en la comunidad o en el hospital, constituyendo Enterobacter y Hafnia, agentes de infección nosocomial en el 5% de los casos. En adultos se considera una causa excepcional de bacteremia, neumonía, infección nosocomial de tejidos blandos, colonización de catéteres centrales, infección postransplante, endocarditis protésica, septicemia con shock y coagulación intravascular diseminada.
Esto es así porque los sujetos con infección por H. alvei, excepto aquéllos con afectación intestinal, suelen tener una enfermedad grave de base, enfermedad pulmonar obstructiva crónica, diabetes mellitus, insuficiencia renal crónica, cáncer o una serología VIH positiva.
Género Ewinella
Ewingella, previamente conocido como Grupo Entérico 40, es un nuevo género en la familia de Enterobacteriaceae y se describió primero por Grimont y colaboradores en 1983. Este género incluye sólo una especie,
En la mayoría de los casos, la importancia de la patogenia de este organismo, aunque sugestivo, no se ha establecido. Recientemente, informes esparcidos de infecciones debidas a E. americana han aparecido en la literatura.
Ahora es más frecuente observar su desarrollo en peritonitis causado por E. americana en pacientes con fases finales de enfermedad renal que sufren la diálisis peritoneal ambulante continua desde hace más de 12 años. La causa primaria de fracaso renal era la enfermedad del riñón poliquístico.
Género Kluyvera
Kluyvera corresponde a un nuevo género llamado: Grupo Entérico 8. Se divide en tres grupos:
? Kluyvera ascorbata, que sería la especie tipo y que se aísla preferentemente de especímenes clínicos, es incapaz de crecer a 5º C, e in vitro es inhibida por cefalotina y carbenicilina. Es test de ascorbato positivo a diferencia de la segunda especie,
? Kluyvera cryocrescens que es negativa ante este test y que se aísla más del medio ambiente que del paciente.
? Finalmente existe un grupo heterogéneo, sin nombre específico llamado Kluyvera especie grupo tres, distinto genéticamente de los anteriores.
Las cepas de Kluyvera tienen las mismas características de la familia Enterobacteriaceae a la cual pertenecen, son bacilos Gram (-) con flagelos perítricos lo que la hacen móviles, catalasa (+) y oxidasa (-), crecen en agar de Mc Conkey, fermentan la glucosa y son indol (+), rojo metilo (+). Vogues Proskauer (-), citrato (+), H2S (-), ureasa (-), fenilalanina deaminasa (-) y arginina dihidrolasa (-), lisina (+) y ornitina descarboxilasa (+).
Es dificil diferenciarlas de Escherichia coli. Según resultados a través del Microscan, pudimos apreciar que es una colonia más seca y rugosa y con un fenotipo de mayor resistencia a antimicrobianos que E. coli. Todavía se requiere mayor información para que podamos adjudicarle un significado clínico a este género.
Género Cedecea
Cedecea davisae es un bacilo gramnegativo, que pertenece a la familia de las Enterobacteriaceae; aunque tiene diferencias fenotípicas con los otros microorganismos de esta familia de bacterias, tiene grandes similitudes con
Es lipasa positiva, siendo resistente a la acción antimicrobiana de algunas cefalosporinas y de la colistina. Se han comunicado aislamientos por este infrecuente microorganismo en esputo, tracto gastrointestinal, heridas de las manos, escroto y ojos y también se ha aislado en algunos casos de bacteriemias. No se ha encontrado a la fecha ningún caso de absceso de puerta de entrada de laparoscopia en el que se haya aislado este microorganismo, pero no es de extrañar que sea un oportunista en éste tipo de técnicas quirúrgicas.
El nombre de Cedecea fue propuesto recientemente para un único nuevo género en el ancho mundo de las Enterobacteriaceae, previamente conocido como Grupo Entérico 15. Los extendidos de Cedecea se parecen a los de Serratia porque ellos son lipasas positivas y resistentes al cephalothin y colistin.
Sin embargo, Serratia difiere de Cedecea al no hidrolizar la gelatina y el ADN. Dos especies se nombraron originalmente en Cedecea: C. davisae y C. lapagei, pero la hibridación de ADN indicó que otro grupo era distinto y debe ser considerado entonces como un tercero adicional.
Género Moellerella
El nombre de Moellerella wisconsensis se propone previamente para un grupo de la familia Enterobacteriaceae llamado los Grupos Entéricos 46. La especie wisconsensis se acuñó porque se aislaron seis de las nueve especies reconocidas en Wisconsin (USA). Estas especies de wisconsensis eran negativas para: la producción del indol, Voges ? Proskauer, producción de SH2, urea, deaminasa de la felilalanina, lisina y decarboxilasa de la ornitina, dihidrolasa de la arginina, la producción de gas de
En cambio, eran positivas para: el rojo de metilo, citrato (Simmons), producción ácida de la lactosa y rafinosa y resistente al colistin. La información clínica sobre un caso de un paciente internado encontrado en USA puede a priori ser asociado con un caso de diarrea del mismo no por su patogenicidad sino por su oportunismo.
En el agar de MacConkey, las colonias de M. wisconsensis eran luminosas y rojas con la bilis precipitada alrededor de ellos y así eran indistinguible de las colonias de Escherichia coli. Los estudios futuros deben enfocar en el aislamiento de este nuevo organismo y su relación a la enfermedad humana, por sobre todo a la trasmisión por los alimentos (ETA).
Género Rahnella
Entre los cambios que ha experimentado el trabajo con bacterias y hongos tenemos los adelantos en la identificación, que ha pasa o rápidamente manual a automatizada, lo que ha permitido crear una serie de bases de datos con las cuales se aumentan las posibilidades de identificación correcta de un organismo. La primera de esas bases de datos es la utilizada por el sistema API de
Unido a esta mejoría en la identificación de los microorganismos y como un paso más adelante, está el hecho de que el futuro en la clasificación de los microorganismos parece dirigirse al uso de los métodos moleculares, ya sea PCR o hibridización. Este futuro ya casi está entre nosotros y técnicas como el ribotipeo o técnicas para la detección de genes de resistencia bacterianos ya son de uso en algunos laboratorios de investigación.
Todo esto ha permitido ampliar la gama de organismos que los laboratorios clínicos pueden identificar, entre ellos los de muy baja frecuencia de aislamiento a nivel mundial, como es el caso de
PD: LA BIBLIOGRAFIA DE TODO ESTE TEMA, QUE INCLUYE EL CRÉDITO FOTOGRÁFICO, ESTA EN MI PODER Y POR SU EXTENSIÓN NO FUE PUBLICADA. NO OBSTANTE, AL QUE LE INTERESE LA MISMA, CON TODO GUSTO ME LA SOLICITA Y YO SE LA ENVIARÉ POR MAIL, MUCHAS GRACIAS.
PD II: LAS PROXIMAS ENTREGAS SEMANALES TRATARAN SOBRE LAS ENFERMEDADES TRANSMITIDAS POR LOS ALIMENTOS ETA(s) BAJO TODOS SUS ASPECTOS, BIOLÓGICOS Y NO BIOLÓGICOS.